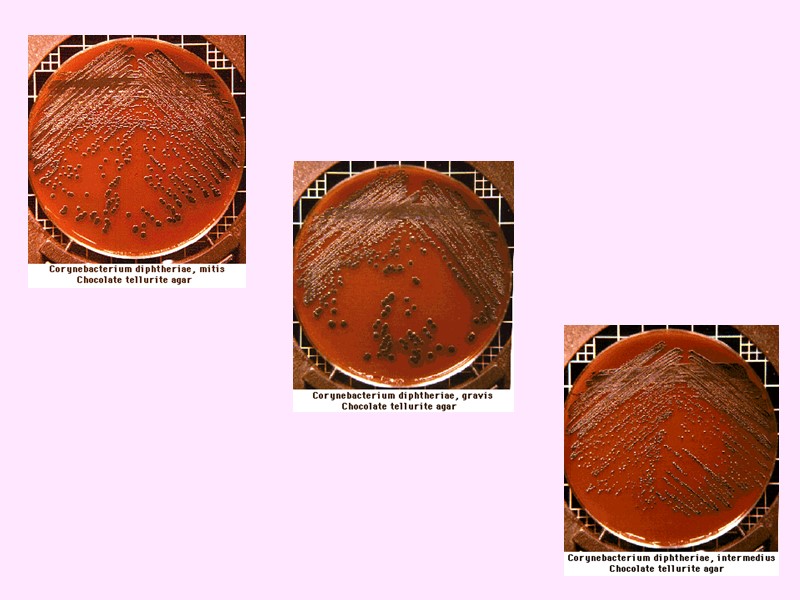
Историческая  справка  1883 г.:  Э. Клебс –  открытие возбудителя дифтерии.

Лекция «Характеристика коринебактерий. Микобактерии» ГОУ ВПО Кировская ГМА


Лекция «Характеристика коринебактерий. Микобактерии» ГОУ ВПО Кировская ГМА Кафедра микробиологии с вирусологией и иммунологией Лектор: к.м.н. Е.И. КОРОТКОВА

План лекции: Коринебактерии – возбудители дифтерии. Общая характеристика микобактерий. Возбудители туберкулеза.

Дифтерия – острое инфекционное заболевание, характеризующееся токсическим поражением сердечно-сосудистой и нервной систем, а также специфическим фибринозным (дифтеритическим) воспалением в месте входных ворот.
Историческая справка 1883 г.: Э. Клебс – открытие возбудителя дифтерии. 1884 г.: Ф. Леффлер - выделил чистую культуру. 1888 г.: Э. Ру, А. Йерсен - дифтерийный токсин. 1895 г.: Э. Беринг, Э. Ру - противодифтерийная сыворотка. 1897 г.: П. Эрлих – применение сыворотки для лечения дифтерии. 1923 г.: Г. Рамон - дифтерийный анатоксин. Г.Н. Габричевский – применение противодифтерийной сыворотки с лечебной целью, организация ее производства в России. А. Йерсен Э. Беринг П. Эрлих

Таксономия Семейство – Corynebacteriaceae Род – Corynebacterium Вид – C. diphtheriae, дифтероиды: C. pseudodiphthericum (палочка Хофманна), С. xerosis, C. ulcerans.

Морфология Прямые или изогнутые палочки (0,3-0,8×1-8 мкм); Спор не образуют; Неподвижны; Имеют микрокапсулу; Расположение бактерий в мазке – под углом друг к другу (в виде V, X, L); На концах булавидные утолщения (зерна волютина – гранулы полиметафосфата); Грамположительные; По Нейссеру: цитоплазма желтого цвета, зерна волютина – синего.

Культуральные свойства Факультативные анаэробы; Оптимальная температура 370С; рН 7,3-8,0; Длительность 12-24 часа; Требовательны к питательным средам: среда Леффлера (свернутая лошадиная сыворотка с добавлением глюкозы) – серовато-кремовые сухие морщинистые колонии по типу «шагреневой кожи»; среда Бучина с хинозолом – плоские темно-синие колонии; Дифференциально-диагностические среды с теллуритом (Клауберг II, Тиндаль) – серовато-черные колонии.

Биохимическая активность Сбраживают с образованием кислоты глюкозу, мальтозу, галактозу; Некоторые варианты ферментируют декстрин, крахмал и гликоген; Не разлагают сахарозу, лактозу и маннит; Восстанавливают нитраты в нитриты; Не гидролизируют мочевину (проба Закса отрицательная); Разлагают цистеин с образованием H2S (проба Пизу положительная); Индол не образуют.

Биовар mitis: Ферментирует глюкозу, мальтозу, не сбраживает сахарозу, крахмал, гликоген и декстрин; Проба Пизу положительная; Восстанавливает нитраты; Проба Закса отрицательная; На средах с теллуритом – мелкие гладкие блестящие полупрозрачные черные колонии с ровным краем; На жидкой среде – равномерное помутнение и порошкообразный осадок; На кровяных средах – зоны гемолиза; Малотоксичен; Вызывает легкую спородическую заболеваемость.

Биовар gravis: Ферментирует глюкозу, мальтозу, крахмал, гликоген и декстрин; Проба Пизу положительная; Восстанавливает нитраты; Проба Закса отрицательная; На средах с теллуритом – крупные сухие матовые плоские серо-черные колонии, приподнятые в центре, с радиальной исчерченностью и неровным краем (напоминают маргаритку); На жидкой среде – пленка, помутнение и крупнозернистый осадок; На кровяных средах – гемолиза ±; Обладает выраженными токсигенными свойствами; Выделяется от больных с тяжелой формой дифтерии, вызывает групповые вспышки.

Биовар intermedius: По биохимическим и культуральным свойствам сходен с биоваром gravis; На средах с теллуритом мелкие сухие матовые серо-черные колонии с неровным краем; На жидкой среде – помутнение с последующим образованием мелкозернистого осадка; Гемолиз на кровяных средах отсутствует.


Дифференциация дифтерийной палочки от дифтероидов

Антигенная структура О-антиген – групповой, липополисахарид клеточной стенки, термостабильный. К-антиген – типовой, представлен капсульными нуклеопротеидами, термолабильный.

Факторы патогенности Токсины: мощный экзотоксин (гистотоксин) оказывает цитотоксическое действие, обладает дермонекротическими и гемолитическими свойствами (синтезируют только C. diphtheriae, лизогенные tox-профагом). Ферменты: гиалорунидаза, нейроминидаза, фибринолизин, лецитиназа. Структурные и химические компоненты клетки: пили I порядка, микрокапсула, Cor-фактор, бактериоцины (корицины).

Резистентность При 600С – погибают за 10 минут; Кипячение – мгновенная гибель; 5% раствор карболовой кислоты – инактивация через 1 минуту. В высохших пленках и кале – 3-4 месяца; На предметах обихода, одежде – до 15 дней; На мягких игрушках – 3 месяца; В воде и молоке – 20 дней; В пыли – до 5 месяцев. Чувствительны к пенициллину, тетрациклину, эритромицину.

Эпидемиология Источник инфекции – больной человек или бактерионоситель. Механизмы передачи инфекции: Аэрогенный (пути – воздушно-капельный и воздушно-пылевой); Контактный (путь – непрямой контактный); Фекально-оральный (путь – алиментарный). Входные ворота: слизистые оболочки носа, зева, гортани, трахеи, бронхов, конъюктивы, наружных половых органов, раневая поверхность. Инкубационный период – 2-10 дней.

Патогенез, клиника, иммунитет Приобретенный иммунитет – стойкий напряженный антитоксический.

Микробиологическая диагностика Исследуемый материал – слизь из зева и носа, пленки с миндалин, раневое отделяемое, кровь. 1. Бактериоскопический метод. 2. Бактериологический метод (основной). Определение токсигенности C. diphtheriae: биологическая проба на животных – внутрикожное введение морским свинкам культуры дифтерийной палочки – некроз в месте введения, последующая гибель животного; заражение куриных эмбрионов (гибель); внесение в культуру клеток (ЦПД); ИФА; ДНК-зонды для обнаружения tox-оперона в геноме; РДП по Илеку и Оухтерлони. 3. Серодиагностика – РПГА, ИФА, РИА, реакция ко-агглютинации, проба Шика. 4. Экспресс-диагностика – РИФ, ИФА, РПГА, реакция ко-агглютинации. 5. Молекулярно-биологический метод – ПЦР (обнаружение tox-гена).

РДП по Илеку и Оухтерлони


Специфическая профилактика Плановая – вакцинами АКДС, АКДС-М и анатоксинами АДС, АДС-М, АД, АД-М. Вакцинация трехкратно в возрасте 3-4,5-6 месяцев; Первая ревакцинация – в 18 месяцев; Вторая ревакцинация – в 7 лет; Третья – в 14 лет; Последующие ревакцинации – каждые 10 лет до 56-летнего возраста.

Специфическое лечение Внутримышечное введение противодифтерийной антитоксической сыворотки, в дозе 10000-40000 МЕ в зависимости от тяжести заболевания, по Безредке. Обязательно – предварительное проведение кожной пробы.

Общая характеристика микобактерий Микобактерии относятся к семейству Mycobacteriaceae, род Mycobacterium (более 40 видов). Прямые или слегка изогнутые палочки размером 0,2-0,6×1-10 мкм. Склонны к ветвлению подобно грибам. Кислото-спирто-щелочеустойчивы. Плохо окрашиваются анилиновыми красителями. Грамположительные. Медленно растут на питательных средах.

Туберкулез – это инфекционное антропозоонозное заболевание, вызываемое микобактериями и характеризующееся развитием специфического гранулематозного воспаления, чаще хроническим течением, многообразием клинических проявлений и поражением различных органов, главным образом дыхательной системы.

Актуальность Туберкулез – это самая распространенная инфекция. Туберкулез – это глобальная проблема всех стран мира (ежегодно в мире регистрируется 8-10 млн случаев первичного инфицирования микобактериями туберкулеза). В России сохраняется высокий уровень заболеваемости туберкулезом. Туберкулез – это инфекция, которая чаще всего является причиной смерти и инвалидности. Туберкулез может поражать любой орган и систему организма.

Причины распространенности туберкулеза: Сокращение объемов финансирования противотуберкулезных программ. Снижение социально-экономического уровня жизни граждан. Распространение лекарственно устойчивых штаммов микобактерий туберкулеза. Дефицит противотуберкулезных препаратов, дорогостоящее лечение. Распространение ВИЧ-инфекции (более 13 тыс. случаев ВИЧ-ассоциированного туберкулеза). Недостатки в работе первичного звена по диагностике и раннему выявлению туберкулеза.

Историческая справка Аретей Каппадокийский, Гиппократ – описали легочную форму; Ибн-Сина – считал туберкулез наследственной болезнью; Фракосторо – указал на его инфекционную природу; 1865 г.: Вильмен – доказана инфекционная природа; 1882 г.: Р.Кох – открыл туберкулезную палочку. Ц. Пирке, А. Кальметт и К. Герен – разработка методов диагностики, профилактики и лечения туберкулеза.

Таксономия Порядок – Actinomycetales Семейство – Mycobacteriaceae Род – Mycobacterium Виды – M. tuberculosis (92%), M. bovis (5%), M. africanum (3%).

Морфология Характерен полиморфизм и склонность к ветвлению: в свежих культурах – прямые или слегка изогнутые палочки размером 0,3-0,6×1-4 мкм; нитевидная форма; кокковидная форма; зернистые формы (зерна Муха, не являются КУБ); фильтрующиеся формы; L-формы. Жгутики отсутствуют; Спор не образуют, имеют микрокапсулу; Кислото-спирто-щелочеустойчивы (клеточная стенка на 46% состоит из липидов в 3-х фракциях: фосфатиды, воски и жирные кислоты – туберкулостеариновая, фтионовая, миколовая и др.); Грамположительны; По Цилю-Нильсену – в красный цвет, зернистые формы – в фиолетовый; Окраска ауромином – желтый цвет.

Культуральные свойства Строгий аэроб; Оптимальная температура 370С; рН 6,4-7,2; Видимый рост M. tuberculosis через 12-25 дней, M. bovis – через 24-40 дней; Рост стимулируется 5-10% СО2 и 0,5% глицерина; Культивируются только на сложных питательных средах с глицерином: среда Левенштайна-Йенсена, среда Петраньяни, среда Сотона.

Культуральные свойства На плотных питательных средах: M. tuberculosis – сухие морщинистые крошащиеся возвышающиеся колонии желтовато-кремового цвета с неровными изрезанными краями; M. bovis – небольшие слегка выпуклые бесцветные колонии с изрезанными краями. В жидких средах: тонкая нежная желтоватая пленка, которая постепенно утолщается, становится морщинистой, ломкой, раствор остается прозрачным.

Культуральные свойства Для выявления корд-фактора: среда Прайса (агар с цитратной кроличьей кровью) – рост в виде кос или плетенных веревок.

Биохимическая активность M. tuberculosis обладает каталазной активностью, уреазой, никотинаминидазой, восстанавливает нитраты, накапливает в среде ниацин (ниациновый тест Конно – среда желтеет). M. bovis тоже обладает уреазой, но не восстанавливает нитраты, не продуцирует никотинаминидазу и не накапливает в среде ниацин.

Антигенная структура Белковые, полисахаридные, липидные компоненты клетки, фосфатиды.

Факторы патогенности Токсины. Токсическими свойствами обладают химические компоненты клетки: туберкулопротеин, липидные фракции, корд-фактор (высокотоксичен). Ферменты: лецитиназа, каталаза, пероксидаза. Структурные и химические компоненты клетки: Миколовая кислота – склеивает микобактерии, образует клетки Пирогова-Лангханса; Корд-фактор – токсическое действие на ткани, блокирует окислительное фосфорилирование на митохондриях, защищает от фагоцитоза, подавляет миграцию лейкоцитов; Липиды (фосфатидный фактор, фтионовая кислота, мураминдипептид, воск Д) и полисахариды - образование эпителиоидных клеток, специфические гранулематозные изменения в тканях; Туберкулопротеин – развитие ГЗТ.

Резистентность Устойчивы к кислотам, щелочам, спиртам, высушиванию (в высохшей мокроте до 2 месяцев). Рассеянный солнечный свет - 8-10 суток, прямой – 5 минут. На белье, книгах – свыше 3 месяцев; в воде – более 1 года; в почве – до 6 месяцев; в желудочном соке – 6 месяцев; в масле – 10 месяцев. Выдерживают температуру жидкого азота (-1900С), при кипячении погибает через 5-7 минут, 500С – 12 часов. 5% карболовая кислота, 1:1000 сулема – 1 сутки, 10% формалин – 12 часов, 5% фенол – 6 часов, 0,05% бензилхлорфенол – 15 минут. Губительно действуют стрептомицин, рифампицин, тубазид, фтивазид, ПАСК.

Эпидемиология Источник инфекции – больной человек и животные. Механизмы передачи: Аэрогенный (пути – воздушно-капельный, воздушно-пылевой); Фекально-оральный (путь – алиментарный); Контактный (путь – непрямой контактный); Вертикальный (путь – трансплацентарный).

Патогенез и клинические особенности 85-95% случаев – туберкулез легких и внутригрудных лимфатических узлов. Остальные случаи – туберкулез костей, суставов, кишечника, мочеполовой системы и т.д. Первичный аффект – специфическая гранулема (бугорок): в центре – зона казеозного некроза с M. tuberculosis, окруженная зоной эпителиоидных и гигантских многоядерных клеток Пирогова-Лангханса, далее вал из лимфоцитов и мононуклеарных фагоцитов.

Патогенез и клинические особенности Первичный туберкулезный комплекс: первичный аффект; лимфангоит; лимфаденит. Первичный очаг окружается соединительнотканной капсулой и обызвестляется – формируется очаг Гона.

Прогрессия 4 путями: По лимфатическим сосудам. Гематогенный путь. Рост первичного аффекта вплоть до казеозной пневмонии. Смешанный путь. Вторичный туберкулез развивается при повторном массивном инфицировании микобактериями, либо эндогенным путем из очага Гона и других локализаций первичного туберкулеза. Патогенез и клинические особенности

Иммунитет Значительный естественный иммунитет. Приобретенный иммунитет – клеточный нестерильный.

Микробиологическая диагностика Исследуемый материал – мокрота, гной, моча, СМЖ, плевральная жидкость, промывные воды желудка, кусочки органов, кровь. Бактериоскопический метод. Бактериологичекий метод (основной). Ускоренный метод Прайса на обнаружение корд-фактора. Биологический метод. Серологический метод – РСК, РПГА, РДП в геле, ИФА, РИА, иммуноблотинг. Молекулярно-биологический метод – ПЦР, ДНК-гибридизация. Аллергологический метод – проба Манту с 2 ТЕ PPD-L.

1890 г.: Р. Кох – алть-туберкулин – накожная градуированная проба Пирке. 1937 г.: Ф. Зейберт – «очищенный протеиновый дериват» - Purified Protein Derivative (PPD-S); 1965 г.: М.А. Линникова (PPD-L) – кожная аллергическая проба Манту. Р. Кох

Проба Манту с 2 ТЕ

Оценка пробы Манту с 2 ТЕ (Через 48-72 часа) Отрицательная – уколочная реакция. Сомнительная – инфильтрат 2-4 мм или только гиперемия любого размера. Положительная – инфильтрат 5 мм и более. Гиперэргическая – инфильтрат 21 мм и более или везикуло-некротическая реакция независимо от размера инфильтрата.

Специфическая профилактика Плановая вакцинация в возрасте 3-7 дней вакциной БЦЖ (BCG – Bacille Calmette Geren) Первая ревакцинация – в 7 лет при отрицательной пробе Манту. Вторая ревакцинация – в 14 лет при отрицательной пробе Манту и не получившим прививку в 7 лет.

Специфическое лечение – не разработано. Неспецифическое лечение – АБ, ХТП: изониазид (тубазид), ПАСК, рифампицин, стрептомицин, этамбутол и др. Специфическое лечение

Лепра (проказа) – это хроническое генерализованное заболевание, характеризующееся специфическим гранулематозным поражением производных эктодермы (кожи, слизистых оболочек, периферической нервной системы) и патологическими изменениями во внутренний органах. Инкубационный период – 3-5 и даже до 20-30 лет. Заражение: длительные и тесные бытовые контакты, воздушно-капельный путь. 1873 г.: норвежский врач Хансен – M. leprae.

M. leprae в мазках располагаются внутриклеточно параллельными рядами в виде «пачек сигарет». Скопления этих групп образуют, «лепрозные шары».

M. leprae – облигатный внутриклеточный паразит, на питательных средах не растет, (заболевание воспроизводится на броненосцах, экспериментальная модель – заражение белых мышей в подушечки лап).
15-1_difteriya._tuberkulez.ppt
- Количество слайдов: 51

